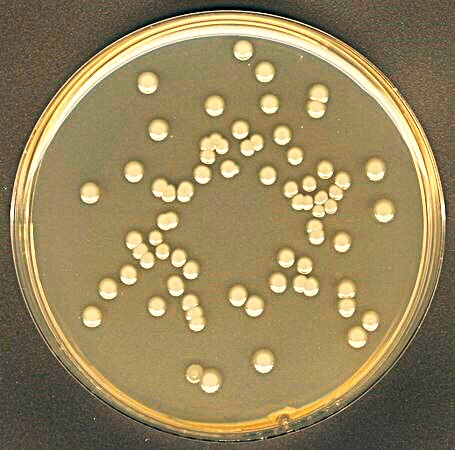
Microbiological Test Plate

Fast, dependable laboratory testing to support product development, release, and compliance.
Fast Turnaround, Cost Effective Testing Services




Testing services aligned with quality and regulatory requirements.
Chemical, Microbiological and Stability Testing




Safety and compliance testing for cosmetics and consumer products.
Safety, Compliance and Quality Testing




 About Us
About Us
Cost-Effective Testing. Fast, Reliable Results.
Welcome to Pentyl Labs, an independent analytical testing laboratory providing efficient, high-quality third-party testing services. Our approach is simple: deliver accurate, reliable results with fast turnaround times and transparent pricing—without compromising scientific rigor or regulatory confidence. We offer a comprehensive range of laboratory testing services, including chemical analysis, microbiological testing, preservative efficacy (PET), stability and accelerated shelf-life studies, safety assessments, HRIPT, regulatory and compliance testing, claim support, and flash point testing. Our services support products from early development through market launch. With modern laboratory instrumentation, streamlined workflows, and responsive technical support, Pentyl Labs helps companies move products forward with confidence. We work closely with our clients to provide practical guidance, clear reporting, and dependable timelines aligned with real-world product and regulatory needs. Browse our service catalog or contact us at [email protected] to discuss your project.

 our Services
our Services
Accurate Testing Built for Regulatory Confidence
 WHY CHOOSE US
WHY CHOOSE US
Reliable Testing. Practical Results.
Our New Jersey-based laboratory provides high-quality, cost-effective testing with fast turnaround times. Using modern instrumentation and streamlined workflows, we deliver accurate, reliable data to support product safety, quality, and compliance. We work closely with our clients to provide clear reporting, responsive communication, and dependable timelines. Contact us at [email protected] to discuss your project. Explore our full service catalog or contact us at [email protected] to discuss your project and testing needs.

Chemical Testing
Comprehensive analytical testing to support formulation, quality control, and compliance requirements.

Microbiological Testing
Microbial testing services to support product safety, quality, and regulatory expectations.
k
Satisfied
customers

K
Satisfied
clients
K
Completed
cases
K
Our
equipment
K
Awards
winning
 Our work Steps
Our work Steps
Our Testing Process
Testing and Analysis
Samples are logged, processed, and tested using appropriate analytical methods.